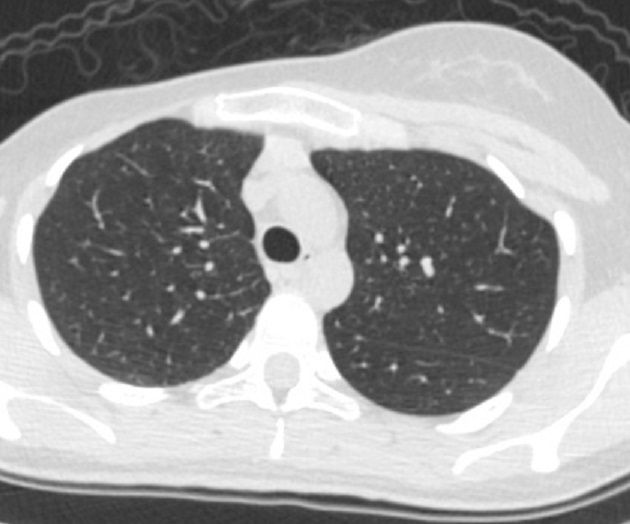

|
Semeiologie pathologie radiologique du thorax
En
generale , la fonction des éléments anatomiques du thorax se
donne de différents syndromes radiologiques correspondence :
- Paroi thoracique : syndrome pariétal.
- Cavité pleurale : syndrome pleural.
- Parenchyme pulmonaire : syndrome alvéolaire,
syndrome interstitiel, syndrome bronchique, syndrome
cavitaire.
- Médiastin : syndrome médiastinal.
Syndrome parietal :
Semiologie , etiologie et sa pathologie radiologique
Le syndrome
pariétal est réalisé par les lésions de la paroi
thoracique, les uns origine des parties
molles, les autres origine osseuse ou des deux en même fois
. Les plus fréquentes des tumeurs des parties molles sont
la lipome, les tumeurs nerveuses, les tumeurs
vasculaires ; les plus fréquentes des lyses osseuses
sont le sarcome d’Ewing avant 20 ans, les métastases
après 50 ans et les lymphomes reste entre ces deux âges.
La radiographie simple est difficile de diagnostic les signes du lesion
graisseux que les lésions osseuses .
Les techniques de choix pour explorer des lesion parietale du thorax sont
: l'échographie, la TDM et l'IRM et la medecine
nucleaire ces qui se donnent le diagnostic positif bien
plus facile .
Lésions des parties molles
parietales
| |
- Ce sont des opacité périphérique,
de densité hydrique, homogène, qui correspond soit à du
tissu, soit peut être à du liquide (pus, sang, œdème,
cellules). |
|
| |
- Son contour est net et bien limite, lorsque le rayon
se met en tangentiellement. |
|
| |
- Lorsque le rayon n’est pas
tangentiel de la lesion : |
|
| |
- Les limites de l’opacité, peuvent être
soit floues, soit nettes sur toute la circonférence ce
qui permet d’affirmer sa situation périphérique,
- Soit
flou d’un côté et nettes de l’autre, dans ce cas il faut
évoquer une localisation pleurale ou pariétale.
|
|
| |
- Le raccordement à la paroi se fait en pente douce sur une
incidence tangentielle. |
|
| |
- Habituellement les lesions parietales avaient le diamètre
horizontal presque aussi grand que son
diamètre vertical et contrairement les opacités pleurales
localisées avaient le diamètre vertical est supérieur au
diamètre horizontal. |
|
| |
- Le signe du liseré pleural peu
connu mais pathognomonique, traduit le refoulement de la
graisse située sur la face externe du feuillet pariétal.
Lorsque l’opacité pariétale se développe vers le poumon
et quelle est vu tangentiellement, elle est parfois
doublée d’un liseré opaque, séparé de la masse par un
halo plus clair d’un ou deux millimètres d’épaisseur. Le
halo clair correspond à la graisse située entre le
fascia endothoracique et la plèvre ; la ligne opaque
traduit le refoulement des deux feuillets pleuraux. |
|
| |
- En scopie, l’opacité pariétale est solidaire des mouvements
du gril costal. |
|
| |
|
|
Lesions osseuses parietales : Se presence :
| |
Elles siègent le plus
souvent sur une côte, mais peut être sieger sur les
autres os du thorax (sternum,
ceinture scapulaire, rachis dorsal) |
|
| |
- Elles sont le plus
souvent ostéolytiques, mais parfois de type
condensant. |
|
| |
-
Une lyse osseuse
souvant sous forme une
ou plusieurs lacunes ; |
|
| |
-
Une érosion costale est à
type d’encoche ; |
|
| |
-
Une fracture
pathologique |
|
| |
-
Une condensation
osseuse |
|
| |
Formation
de image
des parties molles |
|
|
|
| |

 |
|
La formation des images de partie
molle du thorax ( selon Mabille ) :
- Si la lesion être tangentielle son contour est net et bien limite
, bord inferieure est net en pente douce ou plus
aigue . Habituellement les lesions parietales avaient le diamètre
horizontal presque aussi grand que son
diamètre vertical que lesion pleurale ( A )
- S'il y n'a pas tangentielle et etre en face
, la limite de l’opacité, peuvent être
soit floues, hyper opacite dedans à dehors ( B )
- Si la lesion est en oblique soit nettes sur toute la circonférence
ou soit
flou d’un côté et nettes de l’autre,( C )
-
Echographie de la
paroi thoracique
permet de verifie la
solidarite
d'une masse ce qui se lier
avec le gril costal ou avec la partie molle du
thorax ou le poumon. La perte du glissement
pulmonaire en échoscopie peut signaler l'extension
au poumon ou
au contraire
l'origine pulmonaire
- La
TDM et IRM être faciliter le diagnostic
topographique tumoraux et la présence ou non du
liseré graisseux. La TDM ou IRM avec injection de
produits de contraste se donne de déduire des gammes
étiologiques pafaite
|
|
| |
|
|
|
|
| |
 |
|
 |
|
| |
Image echographique d'une
lesion parietal ( metastase costale ) la lesion est
hypoechogen , bord tres nette . Echographie de la
paroi thoracique
permet de verifie la
solidarite
d'une masse ce qui se lier
avec le gril costal ou avec la partie molle du
thorax ou le poumon. La perte du glissement
pulmonaire en échoscopie peut signaler l'extension
au poumon ou
au contraire
l'origine pulmonaire
|
|
Même cas en coupe TDM axiale . Metastase
costale |
|
| |
 Opacite
d' origine pleurale : Image TDM
- En haute : Empyème et abces
- En bas : Mesotheliome
maligne mais envahis la paroi thoracique .
|
|
La
TDM et IRM être faciliter le diagnostic
topographique tumoraux et la présence ou non du
liseré graisseux. La TDM ou IRM avec injection de
produits de contraste se donne de déduire des gammes
étiologiques pafaite :
Les opacités pleurales
dues aux épanchements sont habituellement en «
goutte » avec raccordement obtus en haut et aigu en
bas. Quand ils ne sont pas évidents en standard, ils
sont affirmés en TDM par le signe du « split pleura
»: le produit de contraste souligne la division des
deux feuillets pleuraux viscéral et pariétal, autour
de l'empyème. La distinction avec l'abcès pulmonaire
(sphérique et avec bronchogramme) est aisée
Les tumeurs
pleurales localisées sont plus difficiles à
distinguer du syndrome pariétal que les épanchements.
Les tumeurs à origine de la plèvre pariétale sont
mal différenciées avec syndrome pariétal, d'autant
qu'elles peuvent éroder la côte et donc créer un
syndrome pariétal « secondaire ». C'est le cas des
mésothéliomes malins débutants, non encore
circonférentiels mais pouvant localement
|
|
| |
Formation de
image des lesions osseuses
- Les fracture
peut être difficile à voir sur un cliché en
haute tension.
-
Il faut savoir faire des grils
costaux en basse tension ou en fenêtre osseuse
en numérique TDM .
-
Les obliques sont alors
utiles. L'étude du sternum
reste difficile en radiographie standard
|
|
-
En dehors des
fractures et des lyses osseuse , l'atteinte osseuse peut être
: En
condensation , réaction
périostée lamellaire ou spiculée ou encoche
marginale par
agression ...
- Lesion osseuse des metastase sur TDM souvent
hypodense
- Par la TDM on peut verifier une tumeur à
originr costale .
|
|
| |
 |
|
 |
|
| |
Image
radiologique standard PA pulmonaire de lyse costale
droit d'une lesion metastase costale |
|
Schéma du syndrome pariétal avec lésion osseuse. 1.
opacité en regard d'une ostéolyse costale ; 2. floue
en haut,
bien limitée en bas; 3 raccord
en pente douce |
|
| |
 |
|
 |
|
| |
Syndrome pariétal avec lésion osseuse de hypodense
1/3 posterieure du cote droit (métastase
costale).
Image radiologique
TDM en coupe axiale |
|
Image radiologique TDM d'une tumeur
parietal à origine costale ( metastase costale ) |
|
| |
|
|
|
|
Etiologie : Le
syndrome parietale est en presence pour deas pathologies
à d'origine diverses :
traumatisme , infections, et le plus souvent les tumeurs
. Examen clinique et hiatoire
de la maladie severifier la méthode et techniques d'imagerie
.
La ponction guidée (échographie
ou TDM)
permet une classification anatomopathologique.
| |
Pathologie
congenitale et diverse |
|
Pathologie tumorale
|
|
| |
- Pectus excavatum et carinatum
- Syndrome de Poland
- Encoche costale
- Hernies hiatales
- Calcification parietale
|
|
Tumeur de l'enfant et
aldolescent
- Sarcome d'Ewing
- Tumeur secondaire
- Tumeur begnin
|
|
| |
Pathologie
traumatique |
|
|
|
| |
- Fracture sternocostale
- Hematome extrapleurale
- Lesion iatrogenique de la paroi thoracique
|
|
Tumeur de l'aldulte
- Tumeur des parties molles
- Tumeur osseuse
| |
Tumeur sternale |
|
| |
Tumeurs costales begnins |
|
| |
Tumeurs costales malignes |
|
| |
|
|
|
|
| |
Pathologie
inflamatoire et infectueuse |
|
|
|
| |
- Pelvispodylite ankylosante
- Hyperostose sterno-costo-claviculaire
- SAPHO
- Syndrome de Tierzt
- Tuberculose parietal thoracique
- Osteite
- Echinococcose
|
|
|
|
Pathologie radiologique
parietale :
Pathologie radiologique
congenitale et diverse : Comporte : Pectus
excavatum et carinatum , syndrome de Poland , encroche
costale , calcification parietale et hernie parietale .
Pectus excavatum et carinatum : Pectus
excavatum est une deformation congenitale parietale
du thorax par la depression concave en funnel du sternum ,
en presence frequement 1/300-1/1000 cas et en association
avec Marfan syndrome , Ehlers syndrome , myotonic dytrophie
, sybndrome alcoohol fetale ou scoliose congenitale et
pectus carinatum est la deformation convexe du sternum en
forme de pigeon thorax . Pectus carinatum est une
deformation congenitale parietale du thorax par deformation
en convex en avant du sternum " thorax pigeon " , est à
moindre represence que pectus excavatum et elle se presence
en association souvent avec scoliose , cyphose , syndrome de
Marfan et rare est maladie de Schuermann
Image radiologique analogue du pectus excavatum
sur plain film PA / AP pulmonaire :
Image
radiologique analogue du pectus carinatum sur plain film PA /
AP pulmonaire :
-
Augmentation du diametre antero- posterieure du thorax
-
Deformation en deux forme : forme chondrogladiator (
angle de prostruction est en inferieure du sternum } et
chondromadibrual ( angle de prostruction est en
superieure du sternum }
Image
radiologique TDM et IRM du pectus excavatum et carinatum :
-
Index Haller ( diametre
transverse maximale / diametre antero-posterieure du
thorax sur deux plain film AP et profile ) est de plus
3.25 en cas pectus excavatum . Nomalement etre de
moindre de 2 .
-
Angle de torsion du sternum
de plus 30 degree est egale d'agravation du pectus
excavatum
-
Indice de corection ( IC )
du thorax normale est 10 . De moindre est pectus
excavatum ..
mage radiologique du
pectus excavatum
Syndrome
de Poland :
C'est
une malformation de agenesie mineur ou majeur du muscle
pectoral de
même côté congenitale ,implipque
par la formation de artere subclavian et artere vertecbrale
ipsilaterale . Quand l'agénésie
du pectoral est entière ( majeur ) , il y existe une
absence de glande mammaire chez la fille.
Image radiologique du plain film AP du syndrome de Poland
est aspect de hyperluscence du poumon de même côté et aspect
de unilateral d'absence du grand muscle ou petit muscle
pectoral . C'est une anormalie congenital tres rare de
1/36-50.000 cas et peut en association avec Mobius sydrome .
Clinique
: Aplasia ou hypoplasia
-
Muscle
pectoralis majeur( le plus souvent ) ou muscle
pectoralis mineur
-
Ipsilateral 2th à 5th côte
-
Amastia
, athelia ou amazia ipsilaterale
Anormalie des membres superieure :
- Main petit et
brachysyndactyly
Image radiologique AP
plain film , la TDM , IRM et mammographie sont :
- Asymetrie du thorax et image de hyperluscence du
poumon affecté ipsilateral sur le plain film pulmonaire
- Absence aplasia ou hypoplasia du muscle grand
pectorale ou petit pectorale
- Hypoplasie du sein et du muscle pectoralis sur la
mammographie .
Traitement : Chirugie de recontruction ,
implantation du sein ...
| |
 |
|
Image macroscopique d'une
syndrome de Poland . Aplasia du muscle
pectoralis majeur gauche et deformation asymetrique
legere du cage thoracique |
|
| |
|
|
|
|
| |
 |
|
 |
|
| |
Image radiologique de cliche1
de face AP d'une syndrome de Poland avec aplasia dui
muscle pectoralis droit . Aspect de hyperluscence du
poumon droit est très net |
|
Image radiologique TDM en
coupe axial de aplasia du muscle pectoralis majeur
gauche d'une syndrome de Poland |
|
| |
 |
|
 |
|
| |
Cliche de face PA d'une
syndrome de Poland avec de hypolasia du muscle
pectoralis majeur droit . Ce qui donne une aspect
radiologique est hyperluscence du 1/2 superieure du
champ pulmonaire droit |
|
Même cas en coupe axiale TDM
fenêtre mediastinale . |
|
| |
|
|
Et en fenêtre parenchymateuse ... |
|
Encroche costale :
L’encoche costale est un signe radiologique, il
s’agit le plus souvent d’une érosion focale du bord
inferieur de la côte rarement du bord supérieur. Etiologie
peut en distinguer :
- Encoches d’origine vasculaire : Par la
dilatation des arteres intercostales dans coartation
ismique aortique ou très rare dans fistule
arterioveineuse , thrombose de l’aorte abdominale et
insuffisance circulatoire du membre supérieur et dans le
traitement chirurgical de la tétralogie de FALLOT, une
anastomose dite de BLALOCK
- Encoches d’origine nerveuse :
neurofibromateuse intercostale
- Encoches du bord supérieur sont rare
secondaire à une atteinte des muscles intercostaux dans
la poliomyélite ou amyotrophie musculaire (sclérodermie,
polyarthrite rhumatoïde) et dans
l’hyperparathyroïdie.
- Encoches d’origine inconnue, dites
idiopathiques.
| |
 |
|
 |
|
| |
Dans coartation ismique
aortique , cette lesion due une dilatation des
artere collateral en amont et ses branches ce sont
arteres intercostales droit et gauche . Ce qui
entraine de image de encroche costale au bord
inferieure des cotes |
|
Image radiologique du cliche
analogue pulmonaire PA d'une encroche costale de
bord inferieure des côtes droit et gauche ( flèche
rouge ) d'une coartation ismique aortique . |
|
| |
 |
|
 |
|
| |
Image radiologique PA cliche
de face pulmonaire d'une cartation istmique aortique
avec image de dilatation de aort ascendante ,
dilatation post stenotique de aort descendante ,
double courbe de bouton aortique et image de
encrhoche costale des cotes droites ( flèche rouge ) |
|
Même cas en schematisee , on
peut en vue net image d'encrohe costale des côtes
droites ( en flèche ) et image en double bouton du
cros aortique |
|
| |
|
|
|
|
A suivre
•
Gs Bui BinhTho
<< BACK << >>
NEXT
Page :
1
/
2
/
3
/
4
/
5
/
6
/
7
|
u |